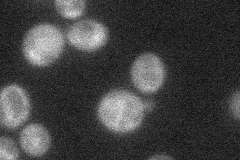
YCL050C
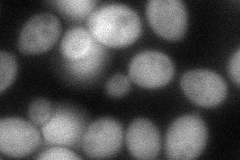
YCL050C
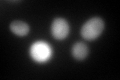
YCL050C
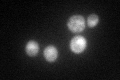
YCL050C

View description
Diadenosine 5',5''-P1,P4-tetraphosphate phosphorylase I (AP4A phosphorylase), involved in catabolism of bis(5'-nucleosidyl) tetraphosphates; has similarity to Apa2p
Localization:
Intensity:
Fold change:
Significance:
-
C’ GFP library in SD

cytosol125.81 -
N' NOP1pr-GFP in SD
cytosol21.0165 -
N' TEF2pr-mCherry in SD

missing0 -
N' NATIVEpr-GFP in SD

missing0 -
N' TEF2pr-VC and Cyto-VN in SD
cytosol79.4809 -
C’ GFP library in SD+DTT
cytosol127.361.01No -
C’ GFP library in SD+H2O2

cytosol154.271.22No -
C’ GFP library in Starvation Media
nucleusN/AN/AYes -
C’ GFP library on the background of Pup2-DaMP

cytosol -
C’ GFP library on the background of CCT mutant

cytosol170.7871.35742No
